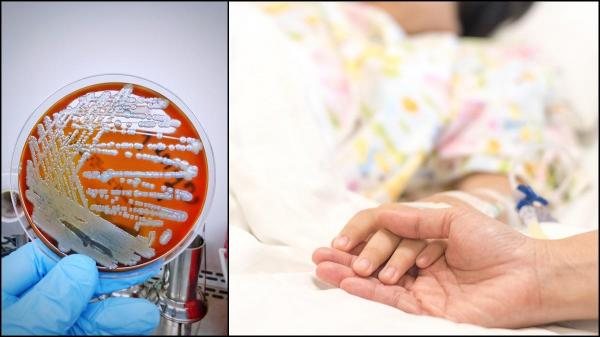
Bacterie ucigaşă, descoperită într-un spray de cameră, comercializat într-un supermarket din SUA. Două persoane au murit, între care un copil

Știri spray camera
Citeste ultimele stiri pe Observator despre Spray Camera. Fii informat cu Observatornews.ro, site de stiri care prezinta cele mai noi informatii, reportaje si evenimente din tara si din lume.
Citeste ultimele stiri pe Observator despre Spray Camera. Fii informat cu Observatornews.ro, site de stiri care prezinta cele mai noi informatii, reportaje si evenimente din tara si din lume.
Un spray de cameră, comercializat într-un supermarket Walmart, a fost asociat cu patru cazuri de infecţie cu o bacterie ucigaşă...
pe 23.10.2021 la 12:11